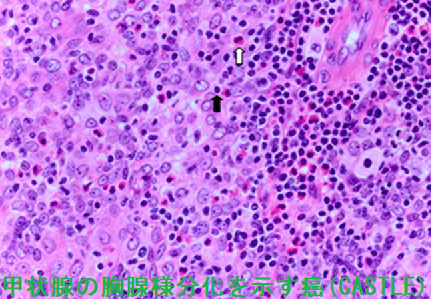
胸腺様分化を示す癌(CASTLE) 組織 胸腺様分化を示す癌(CASTLE) 組織

甲状腺の胸腺様分化を示す癌(CASTLE)[症状,細胞診,組織,鑑別,診断,治療,予後][橋本病 バセドウ病 超音波エコー検査 長崎甲状腺クリニック 大阪]
甲状腺:専門の検査/治療/知見① 橋本病 バセドウ病 甲状腺エコー 長崎甲状腺クリニック大阪
甲状腺専門の長崎甲状腺クリニック(大阪府大阪市東住吉区)院長が海外・国内論文に眼を通して得た知見、院長自身が大阪市立大学(現、大阪公立大学) 代謝内分泌病態内科で得た知識・経験・行った研究、日本甲状腺学会学術集会で入手した知見です。
長崎甲状腺クリニック(大阪)以外の写真・図表はPubMed等において学術目的で使用可能なもの(Creative Commons License)、public health目的で官公庁・非営利団体等が公表したものを一部改変しています。引用元に感謝いたします。尚、本ページは長崎甲状腺クリニック(大阪)の経費で非営利的に運営されており、広告収入は一切得ておりません。
甲状腺・動脈硬化・内分泌代謝に御用の方は 甲状腺編 動脈硬化編 甲状腺以外のホルモンの病気(副甲状腺/副腎/下垂体/妊娠・不妊など) 糖尿病編 をクリックください。
Summary
甲状腺の胸腺様分化を示す癌(CASTLE)は胸腺上皮性腫瘍に類似した甲状腺癌で甲状腺内異所性胸腺癌。50歳頃に多く男女比1:1.3。超音波エコー検査では低エコー・細胞診では扁平上皮様細胞やリンパ球様細胞を認め甲状腺原発扁平上皮癌・甲状腺未分化癌・甲状腺悪性リンパ腫と鑑別難。長期生存する甲状腺未分化癌にCASTLEが含まれる。症状は無痛性腫瘤・反回神経麻痺による嗄声だが呼吸困難や急性腫大、白血球増多は少ない。T細胞マーカーCD5の免疫染色にて鑑別診断。治療は外科的切除で手術後5年の根治率は90%と予後良好。リンパ節転移と周囲組織浸潤があると治療成績は劣る。
Keywords
甲状腺の胸腺様分化を示す癌,CASTLE,甲状腺癌,症状,細胞診,組織,鑑別,診断,治療,予後
甲状腺の胸腺様分化を示す癌(CASTLE;carcinoma showing thymus-like differentiation)は、胸腺上皮性腫瘍に類似した甲状腺癌で、甲状腺内異所性胸腺腫の悪性型とされる極めて稀な腫瘍です。(甲状腺がんの0.1%〜0.15%を占める)
胸腺と下部の副甲状腺が第3咽頭嚢から発生する過程で、胸腺の一部が下部副甲状腺から分離せず、甲状腺下極に遺残し癌化したと考えられます。
甲状腺の胸腺様分化を示す癌(CASTLE)は
- 50 歳前後がピークで、男女比は1 : 1.3 と女性がやや多い
- 細胞診での診断は困難で、甲状腺未分化癌、甲状腺原発扁平上皮癌と間違えて診断されることがある
- 長期生存する甲状腺未分化癌の中にCASTLE が含まれている可能性あり(現在はT細胞マーカーCD5 の免疫染色にて確定診断できます)(World J Surg 1985;9:128-135.)
甲状腺の胸腺様分化を示す癌(CASTLE)の症状は、
- 無痛性腫瘤(88%)、咽頭部不快感・咽頭痛はあっても圧痛を伴わないケース事がある
- 反回神経麻痺による嗄声(24%)
- 甲状腺未分化癌や扁平上皮癌のような呼吸困難や急性腫大、白血球増多は少ない
- 気管浸潤を伴うケースもある[Am J Case Rep. 2019 Dec 10;20:1845-1851.]
[Oncol Lett. 2016 Feb;11(2):1321-1326.]
甲状腺乳頭癌と同時に見つかった甲状腺の胸腺様分化を示す癌(CASTLE)の報告があります。[Ear Nose Throat J. 2021 Dec 6:1455613211060167.]
甲状腺の胸腺様分化を示す癌(CASTLE)の超音波(エコー)画像は、甲状腺悪性リンパ腫、甲状腺未分化癌、甲状腺原発扁平上皮癌と鑑別難で、辺縁不整・境界不明瞭、内部は不均一の低エコー結節(あるいは領域)。[Oncol Lett. 2016 Feb;11(2):1321-1326.]
甲状腺の胸腺様分化を示す癌(CASTLE)の細胞診所見は、甲状腺悪性リンパ腫、甲状腺未分化癌、甲状腺原発扁平上皮癌と鑑別が難しい。[Diagn Cytopathol. 2011 Mar;39(3):204-9.]
甲状腺の胸腺様分化を示す癌(CASTLE)の組織像は、線維性結合組織内で扁平上皮様細胞やリンパ球様細胞が索状・小胞巣状(島状)構造を示す特徴的な組織像です[ここで、甲状腺の胸腺様分化を示す癌(CASTLE)が濃厚になります]。
甲状腺の胸腺様分化を示す癌(CASTLE)の治療は外科的切除が第一選択。手術後5年の根治率は90%と良好で、再発の危険が少ない。[World J Surg. 2018 Jun;42(6):1754-1761.]
リンパ節転移例には、術後放射線外照射治療。[Oncotarget. 2016 Dec 6;7(49):81899-81905.][World J Surg Oncol. 2014 Aug 3;12:247.]
甲状腺の胸腺様分化を示す癌(CASTLE)の予後因子は、治癒切除できたか否かです。リンパ節転移と周囲組織浸潤がある場合の治療成績は劣るため、予後規定因子とされます。[World J Surg. 2018 Jun;42(6):1754-1761.]
リンパ節転移は再発率を上げず、術後放射線療法は再発率を低下させなかった[Oncol Lett. 2016 Feb;11(2):1321-1326.]。
外科切除を拒否され、放射線外照射と温熱療法のみ行っても、甲状腺内から腫瘍が一端消失し、寛解後10年で再発した症例が報告されています。(第54回 日本甲状腺学会 P176 放射線治療と温熱療法にて寛解10年後に再発した胸腺様分化を示す癌(CASTLE)の1例)
甲状腺関連の上記以外の検査・治療 長崎甲状腺クリニック(大阪)
- 甲状腺編
- 甲状腺編 part2
- 内分泌代謝(副甲状腺/副腎/下垂体/妊娠・不妊等
も御覧ください
長崎甲状腺クリニック(大阪)とは
長崎甲状腺クリニック(大阪)は日本甲状腺学会認定 甲状腺専門医[橋本病,バセドウ病,甲状腺超音波(エコー)検査など]による甲状腺専門クリニック。大阪府大阪市東住吉区にあります。平野区,住吉区,阿倍野区,住之江区,松原市,堺市,羽曳野市,八尾市,生野区,東大阪市,天王寺区,浪速区も近く。